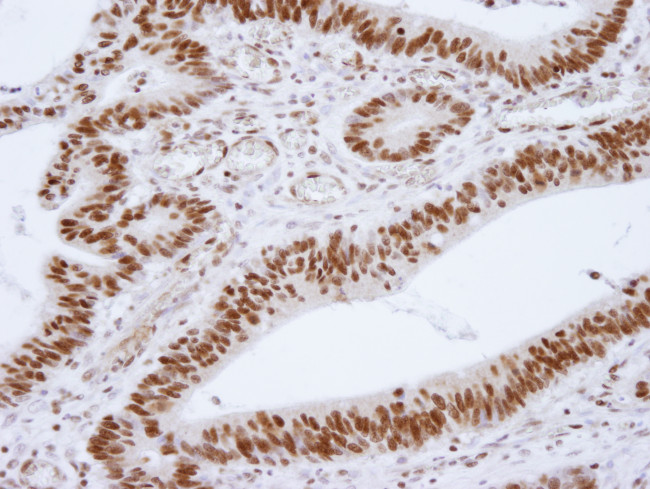
HDAC1 Antibody in Immunohistochemistry (Paraffin) (IHC (P))

Search
Bethyl Laboratories
HDAC1 Polyclonal Antibody
{{$productOrderCtrl.translations['antibody.pdp.commerceCard.promotion.promotions']}}
{{$productOrderCtrl.translations['antibody.pdp.commerceCard.promotion.viewpromo']}}
{{$productOrderCtrl.translations['antibody.pdp.commerceCard.promotion.promocode']}}: {{promo.promoCode}} {{promo.promoTitle}} {{promo.promoDescription}}. {{$productOrderCtrl.translations['antibody.pdp.commerceCard.promotion.learnmore']}}
产品信息
IHC-00056
种属反应
宿主/亚型
分类
类型
抗原
偶联物
形式
浓度
规格
纯化类型
保存液
内含物
保存条件
运输条件
产品详细信息
The recommended shelf life for this product is 1 year from date of receipt.
Based on 100% sequence identity, this antibody is predicted to react with Bovine, Horse, Rabbit, Pig, Panda, Orangutan, Monkey, Gorilla, Chimpanzee, Small-eared galago and Chinese hamster
靶标信息
Histone acetylation and deacetylation, catalyzed by multisubunit complexes, play a key role in the regulation of eukaryotic gene expression. HDAC1 belongs to the histone deacetylase/acuc/apha family and is a component of the histone deacetylase complex. It also interacts with retinoblastoma tumor-suppressor protein and this complex is a key element in the control of cell proliferation and differentiation. Together with metastasis-associated protein-2, HDAC1 deacetylates p53 and modulates its effect on cell growth and apoptosis.
仅用于科研。不用于诊断过程。未经明确授权不得转售。
篇参考文献 (0)
生物信息学
蛋白别名: DKFZp686H12203; HD1; HDAC1; Histone deacetylase 1; Protein deacetylase HDAC1; Protein deacylase HDAC1; protein decrotonylase HDAC1; reduced potassium dependency, yeast homolog-like 1; RP4-811H24.2; unnamed protein product
基因别名: GON-10; HD1; HDAC1; Hdac1-ps; KDAC1; MommeD5; RPD3; RPD3L1
UniProt ID: (Human) Q13547, (Mouse) O09106
Entrez Gene ID: (Human) 3065, (Mouse) 433759